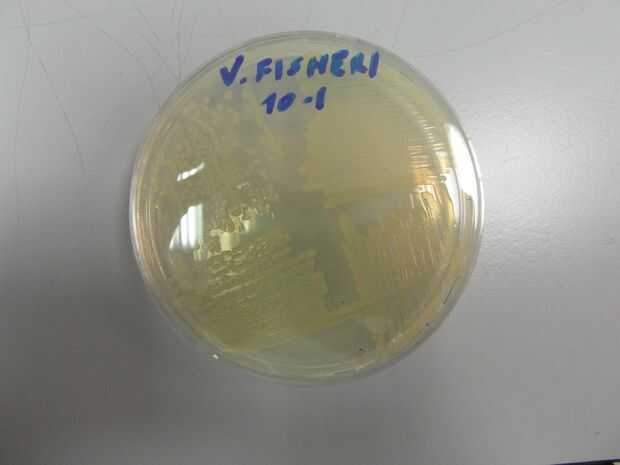
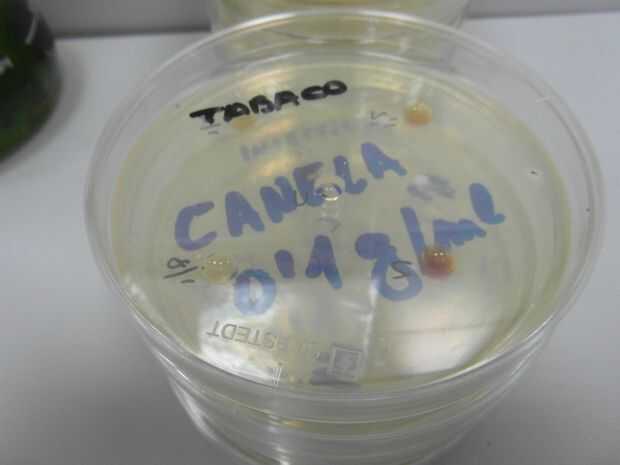
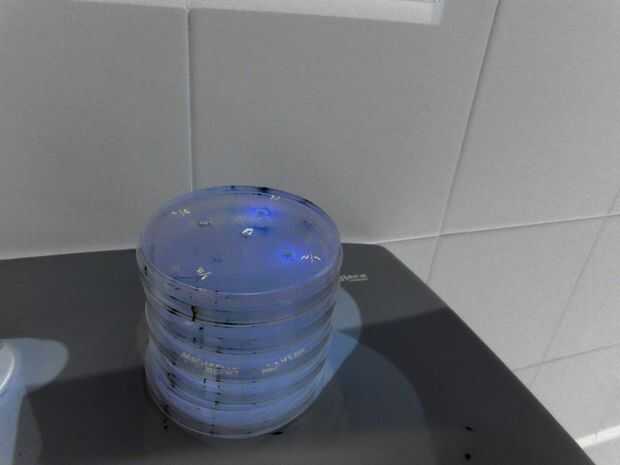

Paso 5: Pruebas de toxicidad (aplicaciones de laboratorio)

Preparación de las sustancias de ensayo
-Hidrofílico: Peso de la sustancia, se desintegran con un mortero o stomacher y diluir en solución salina.
-Hidrofóbica: Peso de la sustancia, que se desintegró con un mortero o stomacher y diluido en disolvente orgánico (etanol). Agregar 10 ul de muestra en un disco de papel. Seco por 24 h (o en un horno) para eliminar el etanol.
Inhibición de la bioluminiscencia inhibiendo la cadena respiratoria.
-Ajustar la concentración de una cultura de Vibrio fischeri a una concentración aproximada de 108 UFC / mL (correspondiente a aproximadamente de turbidez 0.5 de McFarland).
-Plantación de Fischeri del vibrión en una placa TSA salina (2% NaCl) utilizando una esponja o una espátula de Digralsky.
-Incubar la placa a 22 ° C durante 24 h.
-Una vez que las bacterias cultivadas, depositado en la placa de 10 ul de la sustancia a la concentración deseada. Espere 15 minutos hasta que la gota se seca.
-Observar la disminución de la bioluminiscencia en la zona afectada por la gota de la sustancia de ensayo en condiciones de oscuridad.